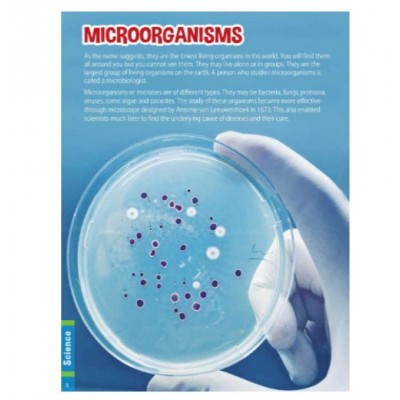
(7-12 years old) children's book
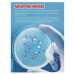
(7-12 years old) children's book

(7-12 years old) children's book
Synopsis
Encyclopedia is a visual kaleidoscope of a diverse range of subjects that the curious and sharp child is always keen to learn about. It contains the mysteries of Space and Science, The animal world and the complexities of the human body. It also deals with the histories of amazing ancient civilisations, as well as ocean- in a nutshell, it contains all that would satisfy the young mind. This book talks about science.
Children's Encyclopedia : Science
Out of Stock
Product Description
- Publisher: Pegasus
- Categories: None
- Barcode: 9788131958728
Qty
Share


.png)